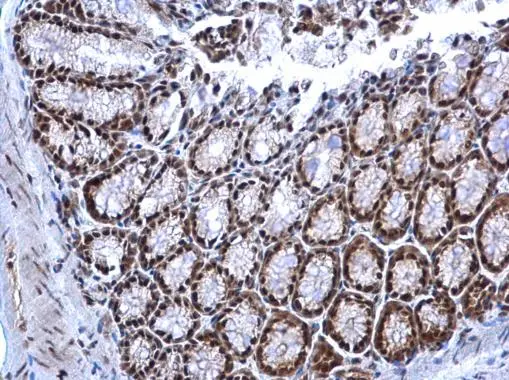
NRF1 antibody detects NRF1 protein at nucleus on mouse colon by immunohistochemical analysis. Sample: Paraffin-embedded mouse colon. NRF1 antibody (GTX103179) dilution: 1:500. 
 Antigen Retrieval: Trilogy? (EDTA based, pH 8.0) buffer, 15min

![NRF1 antibody immunoprecipitates NRF1 protein in IP experiments. IP samples: 293T whole cell extract A. Control with 4 μg of preimmune Rabbit IgG B. Immunoprecipitation of NRF1 protein by 4 μg NRF1 antibody (GTX103179) 10 % SDS-PAGE The immunoprecipitated NRF1 protein was detected by NRF1 antibody (GTX103179) diluted at 1:1000. [EasyBlot anti-rabbit IgG (GTX221666-01) was used as a secondary reagent] NRF1 antibody immunoprecipitates NRF1 protein in IP experiments. IP samples: 293T whole cell extract A. Control with 4 μg of preimmune Rabbit IgG B. Immunoprecipitation of NRF1 protein by 4 μg NRF1 antibody (GTX103179) 10 % SDS-PAGE The immunoprecipitated NRF1 protein was detected by NRF1 antibody (GTX103179) diluted at 1:1000. [EasyBlot anti-rabbit IgG (GTX221666-01) was used as a secondary reagent]](https://www.genetex.com/upload/website/prouct_img/normal/GTX103179/GTX103179_41584_IP_w_23060119_430.webp)
NRF1 antibody immunoprecipitates NRF1 protein in IP experiments. IP samples: 293T whole cell extract A. Control with 4 μg of preimmune Rabbit IgG B. Immunoprecipitation of NRF1 protein by 4 μg NRF1 antibody (GTX103179) 10 % SDS-PAGE The immunoprecipitated NRF1 protein was detected by NRF1 antibody (GTX103179) diluted at 1:1000. [EasyBlot anti-rabbit IgG (GTX221666-01) was used as a secondary reagent]
NRF1 antibody
GTX103179
ApplicationsImmunoFluorescence, ImmunoPrecipitation, Western Blot, ImmunoCytoChemistry, ImmunoHistoChemistry, ImmunoHistoChemistry Paraffin
Product group Antibodies
ReactivityHuman, Mouse, Rat
TargetNRF1
Overview
- SupplierGeneTex
- Product NameNRF1 antibody
- Delivery Days Customer9
- Application Supplier NoteWB: 1:500-1:3000. ICC/IF: 1:100-1:1000. IHC-P: 1:100-1:1000. IP: 1:100-1:500. *Optimal dilutions/concentrations should be determined by the researcher.Not tested in other applications.
- ApplicationsImmunoFluorescence, ImmunoPrecipitation, Western Blot, ImmunoCytoChemistry, ImmunoHistoChemistry, ImmunoHistoChemistry Paraffin
- CertificationResearch Use Only
- ClonalityPolyclonal
- Concentration1.52 mg/ml
- ConjugateUnconjugated
- Gene ID4899
- Target nameNRF1
- Target descriptionnuclear respiratory factor 1
- Target synonymsALPHA-PAL, nuclear respiratory factor 1, alpha palindromic-binding protein
- HostRabbit
- IsotypeIgG
- Protein IDQ16656
- Protein NameNuclear respiratory factor 1
- Scientific DescriptionThis gene encodes a protein that homodimerizes and functions as a transcription factor which activates the expression of some key metabolic genes regulating cellular growth and nuclear genes required for respiration, heme biosynthesis, and mitochondrial DNA transcription and replication. The protein has also been associated with the regulation of neurite outgrowth. Alternate transcriptional splice variants, which encode the same protein, have been characterized. Additional variants encoding different protein isoforms have been described but they have not been fully characterized. Confusion has occurred in bibliographic databases due to the shared symbol of NRF1 for this gene and for nuclear factor (erythroid-derived 2)-like 1 which has an official symbol of NFE2L1. [provided by RefSeq]
- ReactivityHuman, Mouse, Rat
- Storage Instruction-20°C or -80°C,2°C to 8°C
- UNSPSC41116161
![NRF1 antibody detects NRF1 protein at nucleus by immunofluorescent analysis. Sample: HeLa cells were fixed in 4% paraformaldehyde at RT for 15 min. Green: NRF1 stained by NRF1 antibody (GTX103179) diluted at 1:500. Red: alpha Tubulin, a cytoskeleton marker, stained by alpha Tubulin antibody [GT114] (GTX628802) diluted at 1:1000. Scale bar= 10μm. NRF1 antibody detects NRF1 protein at nucleus by immunofluorescent analysis. Sample: HeLa cells were fixed in 4% paraformaldehyde at RT for 15 min. Green: NRF1 stained by NRF1 antibody (GTX103179) diluted at 1:500. Red: alpha Tubulin, a cytoskeleton marker, stained by alpha Tubulin antibody [GT114] (GTX628802) diluted at 1:1000. Scale bar= 10μm.](https://www.genetex.com/upload/website/prouct_img/normal/GTX103179/GTX103179_44601_20220401_ICC_IF_w_23060119_828.webp)

![NRF1 antibody [HL3307] detects NRF1 protein by immunohistochemical analysis. Sample: Paraffin-embedded mouse tissues. NRF1 stained by NRF1 antibody [HL3307] (GTX641069) diluted at 1:200. Antigen Retrieval: Citrate buffer, pH 6.0, 15 min Corresponding RNA expression data for the same tissues are based on NCBI.](https://www.genetex.com/upload/website/prouct_img/normal/GTX641069/GTX641069_T-45544_20241028_IHC-P_Multiple_M_24111918_152.webp)
![Various tissue extracts (50 μg) were separated by 10% SDS-PAGE, and the membrane was blotted with NRF1 antibody [HL3308] (GTX641070) diluted at 1:1000. The HRP-conjugated anti-rabbit IgG antibody (GTX213110-01) was used to detect the primary antibody.](https://www.genetex.com/upload/website/prouct_img/normal/GTX641070/GTX641070_T-45544_20240927_WB_M_R_24100318_344.webp)